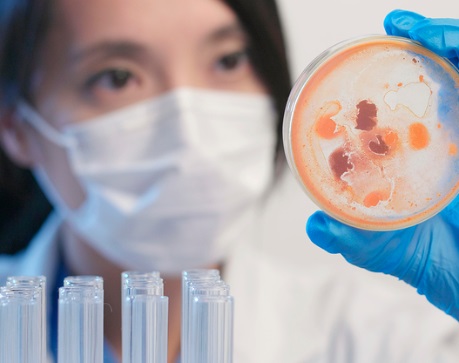

Para impulsar la campaña, se ha creado un vídeo que ya se encuentra colgado en Youtube (https://www.youtube.com/watch?v=mHKVzFC8Qlo), que pretende crear conciencia para recaudar la mayor ayuda económica posible.
De este modo, estas compañías confían en que esta campaña permita complementar otras iniciativas muy necesarias que ya se han puesto en marcha desde diferentes ámbitos, mirando al futuro, para ayudar a desarrollar un reto científico sin precedentes, el desarrollo en un corto plazo de una vacuna contra el COVID-19
“En momentos críticos, es donde tenemos que dar lo mejor de nosotros mismos, tenemos un gran reto por delante y toda ayuda es poca, de ahí que decidiéramos volcarnos en este proyecto y aprovechar nuestra plataforma, para poner nuestro granito de arena tan urgente y necesario como poner fin a la lacra del Covid-19, sin duda, es un honor hacerlo en colaboración con CSIC”, comenta Juan Antonio Balcázar, CEO de Housers. Por su parte, José María Martín, CEO de Paymatico, resalta que se trata de una iniciativa orientada a la investigación en colaboración con el CSIC. “Creemos que la mejor forma de llevar a cabo esta acción es con una entidad pública que está liderando la lucha contra este virus y esperamos que logre el objetivo con el que nace, dedicar recursos directamente a la investigación”, añade.
Este proyecto de recaudación de fondos pretende mirar hacia el futuro y colaborar en la búsqueda de una vacuna contra esta pandemia, totalmente necesaria para garantizar nuestro futuro, según destacan las cinco empresas promotoras. Alberte Santos, CEO de Evercom, afirma que “las situaciones extraordinarias requieren de esfuerzo y solidaridad. El mundo entero vive una lucha contra la pandemia ocasionada por el COVID-19 y debemos colaborar, por eso pensamos que impulsar esta campaña es más necesario que nunca”.
El CEO de Royal Comunicación, Juanjo López, añade que “en la fase de la crisis en la que estamos es el momento de concentrar todos nuestros esfuerzos en descubrir una vacuna”, mientras que Arancha de las Heras, Presidenta de Universidad UDIMA, concluye que “nuestra esperanza es que la iniciativa tenga la mayor visibilidad posible, con el fin de recaudar la cifra más alta a la que podamos aspirar”.
¿Te unes al #ObjetivoVacuna?

Si (
Si ( No(
No(



















